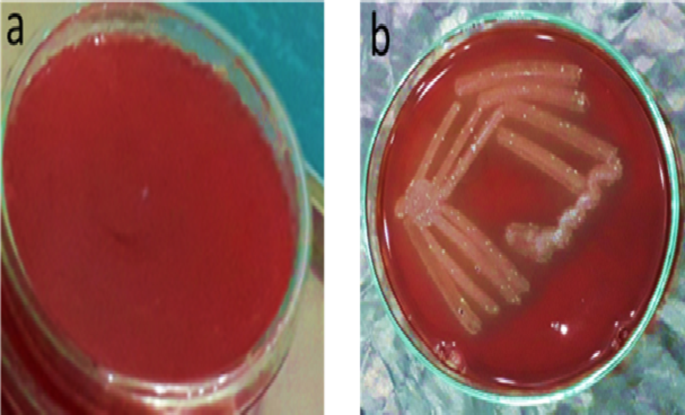
Fig. 6
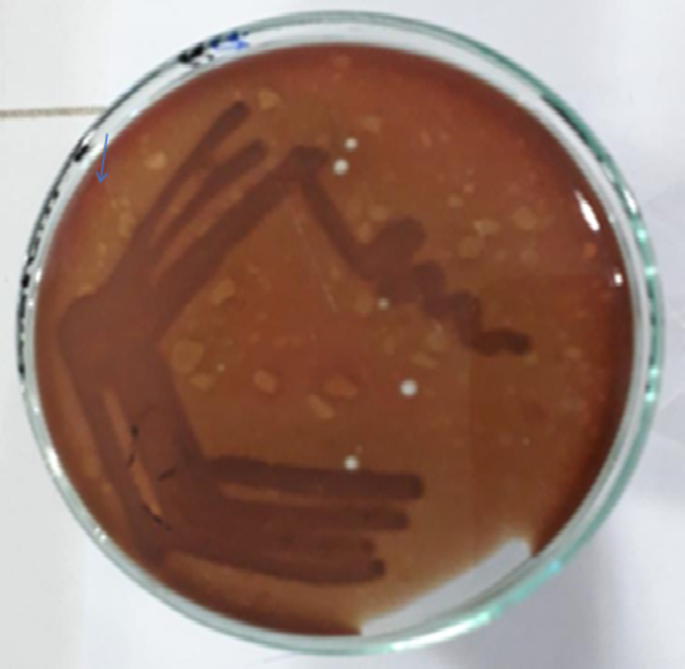
Fig. 11
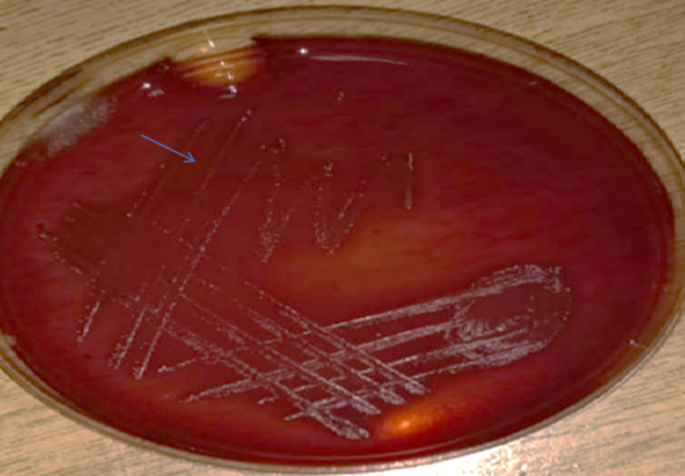
Fig. 12

Abstract
The relationship between Streptococcus mutans and dental caries has been a key focus of research due to the widespread prevalence of caries in humans. In this study, we have investigated the antimicrobial activity of Chenopodium murale (C. murale) extract against Streptococcus mutans by the application of 10 µL of ethanolic extract. The minimum bactericidal concentration test was used for antimicrobial sensitivity by the application of ethanolic extracts of C. murale. The zone of inhibition diameter made by the extract of C. murale, was measured at 12 mm and compared with the standard reference ampicillin and clindamycin antibiotic drugs, measured at 20 mm and 30 mm, respectively. Moreover, the FTIR analysis showed alkyl halide, phenyl, carbonyl, alkane, amines, and alcohol functional groups in C. murale extract. The C. murale plant extract has significant and comparable therapeutic efficacy with reference to the ampicillin reference drug against the bacterial strain Streptococcus mutans, on account of scavenging bond stretches with fewer side effects owing to its natural origin. Further, presence of coumarin in the pure extract of C. murale was confirmed by TLC method. The anti-Streptococcus mutans activity of the C. murale ethanolic extract was found with the MIC of 1.469 mg/mL and MBC of 4.260 and cariogenic properties of Streptococcus mutans linked to pH drop was also inhibited significantly. Our study clearly indicated that this plant extract thus can potentially be used as a commercialized product in near future for the prevention of dental caries.
Similar content being viewed by others
Introduction
Throughout the world, infections of the oral cavity are known to be the main issues related to health1. The loss of minerals in the tooth structure results from the disturbance of the balance within re-mineralization and demineralization that ultimately leads to cavitation2. Streptococcus mutans is the significant supporter belonging to the oral microbiota of early times that provides attachment to other bacteria of the oral cavity for biofilm formation, i.e., dental plaque. Further, more than one hundred species of bacteria among humans and 700 plus strains of bacteria have been isolated3. In developing countries, herbal medicine has been a natural remedy used alternatively in primary health care4. As given in the reports of the WHO, around 80% of the total population of the world uses vegetable extracts or herbal medicines for treatment5.
There is continuity in the demand for a lot of drugs taken from plant sources. Hence, it is important for the systematic assessment of plants being utilized in traditional medicine for many diseases. Therefore, for promising biological activity, there is no requirement for screening medicinal plants6. A species of plant known as Chenopodium murale (Syn. C. murale) with local names like sowbane, salt-green Australian spinach, and nettle-leaved goosefoot belongs to the amaranth family7. Streptococcus mutans induces dental caries in humans. It is the primary cause of dental caries and cavity development in humans. Chenopodium murale is an annual herbaceous plant that attains a height of 1–3 m, characterized by a greenish-yellow stem that is frequently branched at the base. The leaves are rhombic-ovate to lanceolate, about 2–5 cm in length, possessing a waxy feel and a sharp apex. The plant generates little, greenish-yellow blossoms in compact, spherical clusters8. This plant species is known to be native to parts of Northern Africa and Europe, and it is widespread worldwide, especially in subtropical and tropical regions, because of its easy introduction9. There are 200 species of the genus Chenopodium10. The significance of Chenopodium species is because of their wide range of medicinal characteristics. Some flavonoids taken from C. murale demonstrated antihypertensive activity11.
Multiple investigations have proven the antibacterial efficacy of C. murale. Its extracts have demonstrated effectiveness against many bacterial species, including Escherichia coli, Bacillus subtilis, and Staphylococcus aureus, substantiating its historical application as an antibacterial treatment12. Moreover, silver nanoparticles synthesized from C. murale leaf extract have antibacterial and antioxidant characteristics. In this context, the extract serves as a reducing agent to promote the formation of silver nanoparticles, so augmenting its antibacterial efficacy. Chenopodium album Linn. exhibits notable antibacterial efficacy, especially against Escherichia coli, Pseudomonas aeruginosa, Bacillus subtilis, Candida albicans, and Candida glabrata. Phytochemical study verified the existence of bioactive components, such as alkaloids and flavonoids, which enhance its efficacy. This highlights the plant’s potential for further biological evaluation and conventional medical use. C. murale (Syn. Chenopodiastrum murale) exhibits notable antifungal efficacy against Candida albicans, evidenced by its capacity to diminish fungal burden in an oral candidiasis paradigm involving immunosuppressed rats. The fresh leaf juice (CMJ) augmented neutrophil production and increased essential immunomodulatory cytokines, suggesting its promise as a natural therapeutic alternative. LC-MS/MS study found 42 bioactive chemicals, indicating that flavonoids and other components contribute to its antifungal properties. Throughout the years, several natural substances have been investigated for their potential antibacterial and re-mineralizing properties, presenting a viable alternative to traditional therapies. Coumarin, a naturally occurring chemical present in several plants, exhibits antibacterial and anti-inflammatory effects, positioning it as a possible option for the treatment of dental caries. The choice of coumarin for comparison with C. murale extract in the treatment of dental caries is grounded in its well proven antibacterial properties. Coumarin has demonstrated the ability to suppress the proliferation of oral infections, including Streptococcus mutans, a primary factor in dental caries13. The prime goal of our study was to investigate the antibacterial activity of C. murale leaves’ ethanolic extract against dental cavity-causing S. mutans. However, there is no scientific investigation of C. murale against S. mutans. In this research, we reported the scientific evidence on C. murale antibacterial activity against dental caries-causing S. mutans.
Materials and methods
Sampling of saliva samples
This is certified that patients’ proforma-based ethical permission and informed consent was obtained for the collection of saliva samples from patients and the study was carried out in compliance with guidelines of EU Directive 2001/20/EU for human experiments and under guidelines or the National Research Council’s Guide for the Care and Use of human and received approval from the Ethical Committee. The Women University Multan under the approval number WUM/UREC/20–00028. This is to certify that there are no human images, videos, names, or any other form of human identification included in this study, which was conducted under the ethical guidelines of the Declaration of Helsinki.
Sampling was conducted at Bakhtawar Amin Medical and Dental College, Multan. A total of 50 saliva samples were collected for the isolation of Streptococcus mutans from the oral cavity microbiota. Samples were collected only from those patients who were suffering from dental caries. Patients infected with diseases other than dental caries were excluded in the study.
Sample collection
For the isolation of Streptococcus mutans, saliva samples were collected in 2 mL autoclaved eppendorf tubes under sterile conditions. Eppendorf tubes were then placed in an ice pack to maintain the samples’ temperature in order to avoid temperature fluctuations in the course of sample transportation. Samples were transported to the research laboratory of the Department of Microbiology and Molecular Genetics at the Women University Multan and stored at 4 °C before further experimental proceedings.
Culturing bacterial strains
Preparation of blood agar
Blood agar purchase of Condalab barand and sheep blood was used for culturing bacterial strains from saliva samples of dental caries. It was prepared by adding 10 mL of blood to 100 mL of nutrient agar (Condalab). Nutrient agar (N-agar) was prepared by adding all of the ingredients to distilled water, followed by gentle mixing by stirring the mixture so that all the components get dissolved. It was then autoclaved at 121 °C and 15 psi (pressure) for 15 min. After autoclaving, N-agar was allowed to cool to 45–50 °C while it was still in a liquid state. Then 10 mL of blood was added to the nutrient agar, avoiding air bubble formation. Then this mixed blood agar medium was poured into sterilized petri dishes and allowed to solidify. Petri plates were then stored at 4 °C until used for swabbing saliva samples13.
Isolation of bacterial strains
Saliva samples were then swabbed with the help of sterilized cotton swabs onto blood agar in a biosafety cabinet (BSC) to avoid contamination of Petri plates and samples. The petri plates were then incubated for a period of 18–24 h in an incubator at 37 °C.
Purification of bacterial strains on L-agar
L-agar medium (HiMedia M001-500G Nutrient Agar, 500 g purchased and was used for sub-culturing bacterial strains to obtain a pure colony. The petri plates were then placed in an incubator at 37 °C for 18–24 h. A schematic representation of bacterial stain culturing procedure is shown in Fig. 1.
A schematic representation of bacterial stains culturing.
Gram staining procedure
The bacterial identification was carried out through Gram’s staining technique as shown in Fig. 2. Cell shape and size were observed by light microscopy. This technique is used to differentiate gram-positive bacteria from gram-negative bacteria. This technique is primarily used for cell size and cell shape determination. The specified strains of culture were gram-stained and were observed by a light microscope under an oil immersion lens. Bacterial strains of 24-hour-old culture were processed using this staining technique13,14.
Gram staining procedure carried out for the dental caries’ sample testing purpose.
Catalase test
The catalase test was performed to distinguish different bacterial strains from other oral microbes in saliva samples. In this test, a sterilized loop of metal wire was used to pick up and transfer a small colony from a fresh culture to a clean, dry glass slide. Then a small drop of H2O2 was placed on the slide and observed carefully. No bubble formation was observed as no catalase enzyme was being produced. The catalase enzyme was absent in all bacterial strains; therefore, there was no breakdown of H2O2 into water and oxygen. So, no oxygen bubbling was observed15.
Plant extract and stock solution preparation
Leaves of Chenopodium murale (C. murale) were collected from the Mattital campus area of The Women University, Multan with the permission of champus incharge concerning letter No.Wum/zool/08/022017. Catalog #: FoPK204417; Occurrence ID: FoPK204417; Secondary Catalog #: KUH; Taxon: Chenopodium murale L.; Family: Amaranthaceae. The information in open herbarium was used as a reference by botanist Dr.Abida Aziz, department of botany, The Women University Multan. A stock solution of C. murale leaf extract was prepared by crushing fresh, cleaned leaves into a fine powder. The powder was subsequently extracted using ethanol at 50 mg/mL and let to macerate for 72 h at ambient temperature with periodic agitation. Subsequent to extraction, the mixture underwent filtration to eliminate solid particulates, and the filtrate was concentrated using evaporation. The concentrated extract was diluted with ethanol to attain a final concentration of 50 mg/mL and kept at 4 °Cfor subsequent experimental usage as shown in Fig. 3.
Step by step description of plant leaves extract (Chenopodium murale) preparation.
Extract yield calculation
The yield of the extract can be calculated using the following formula:
where Weight of Extract is the mass of the concentrated extract obtained after evaporation and Weight of Dry Leaves is the mass of the dried powdered leaves used for extraction.
Antibacterial activity on Muller Hinton agar
The purified colonies of bacterial strains 24 h old grown on L-agar were picked and streaked on MHA with the help of sterilized cotton buds. The agar well-diffusion technique was applied to test the bacteriostatic activity of C. murale against Streptococcus mutans. Its antibacterial activity was compared with the standard antibiotics; ampicillin and clindamycin (Merck) against S. mutans by the disc-diffusion procedure.
Agar well-diffusion method
In this method, strains from 24-hour-old cultures were streaked on Mueller Hinton Agar. It was followed by well formation in MHA. 10 µL of ethanolic extracts of C. murale were suspended in respective wells. Then the petri plates were placed in an incubator at 37 °C for 24–48 h for bacterial growth as well as for the determination of the bacteriostatic activity of extracts by measuring the diameter of the zone of inhibition around each well as shown in Fig. 4.
A schematic representation of antibacterial activity methods on Muller Hinton Agar.
Disc-diffusion method
Bacterial strains from 24-hour-old cultures were streaked on petri plates, and antibiotic discs were placed with disk dispensers on the agar surface. Then the petri plates were placed in an incubator for 24 h at 37 °C for bacterial growth, and the effectiveness of antibiotics against bacterial strains was determined by measuring the diameter of the inhibition zone around each disk as shown in Fig. 4.
MIC (minimum inhibitory concentration) and MBC (minimum bactericidal concentration)
The minimum inhibitory concentration was obtained using microplate dilution. To a concentration of 8 mg/mL, crude plant extracts were again dissolved in a mixture of 50% distilled water and 50% solvent, namely acetone (AC). In a 96-well plate, 100 µL of Chenopodium murale and gentamicin (as positive control) were mixed with purified water. Each well plate received 100 µL of bacterial suspension that has been standardized to McFarland standard no.0.5. In these studies, plant extract at the following quantities were used: 2, 1, 0.5, 0.25, 0.125, 0.062, 0.031, and 0.015 mg/mL respectively. For 24 h, wrapped plates were left to incubate at 37 °C. 40 µL of p-iodonitrotetrazolium violet was diluted in distilled water and put to the well plate. The wells were then incubated at 37 °C for 30 to 45 min to show growth. A pink or red hue was used to indicate the presence of bacterial growth, whereas clear wells showed that the plant extract was inhibiting bacterial development. The experiment was carried out three times in quadruplicate (Nkala et al., 2019).
TLC (Thin layer chromatography) analysis
The plant extracts; C. murale (50 mg/mL) and the phytochemical standards; Coumarin (Merck,0.1 mg/mL) were spotted on TLC plate covered with a sheet of aluminum coated silica gel 60. The TLC plate containing the mobile phase in a ratio of 3: 4: 1: 1 (% v/v) for following solvent (toluene: ethyl acetate: methanol: formic acid) was dipped in a glass container. TLC plate was dried at room temperature. Rf-values were detected with the help of a chromatogram. This test was performed to check presence of active coumarin in the extract having high antibacterial properties for the treatment of dental carries16.
FTIR analysis of Chenopodium murale extract
The FTIR spectra of C. murale extract were recorded in the range of 4000 to 400 cm−1 using a FTIR spectrometer (Perkin Elmer Spectrum Two, Waltham, Massachusetts, USA). Each spectrum was obtained by averaging multiple scans to enhance signal clarity. The presence of specific functional groups such as alkyl halides, phenyl, carbonyl, alkane, amines, and alcohols was analyzed and compared to known reference spectra17.
To carry out this assay, the suspensions of S. mutans were prepared at the concentration of 7.5 × 10−8 CFU/mL following with solution of KCl from Sigma (50 mM) and MgCl2 Sigma (1 mM) washing and this group was considered as control. Secondly same suspension was prepared again and mixed with the pure extract according to their MICs and considered as treated group. The pH of prepared suspension was adjusted to 7.2–7.4 and a glucose solution (0.5% w/v) was added. The pH of suspensions was constantly monitored for 60 min. The changes of pH was considered as pH drop18.
Statistical analysis
The statistical analysis was conducted by one-way analysis of variance (ANOVA). The data were considered as significant difference when p-value is less than 0.05.
Results
Sample collection
A total of 50 saliva samples (Fig. 5) were collected from Bakhtawar Amin Medical and Dental College, Multan.
Saliva sample of dental caries.
Isolation of bacterial strain
Bacterial strains were isolated from saliva samples on a differential medium like blood agar (Fig. 6a, b). The colonies were further purified on L-agar medium.
(a) Blood agar medium. (b) Isolation of bacterial strains.
Morphological characterization of bacterial strains
Different colonies of bacteria were characterized based on their colony morphology. Small, regular smooth colonies were observed on the culture media used.
Biochemical characterization of bacterial strains
The bacterial strains were characterized by biochemical tests to determine their specific species.
Gram’s staining test
The bacterial strains were Gram-stained, and they all showed positive results of Gram staining. The bacteria appeared round in shape and purple in color when observed under an electron microscope (Fig. 7). Gram Staining test is used to differentiate between Gram-negative and Gram-positive bacteria based on their cell wall composition. Gram positive bacteria have thick peptidoglycan in their cell wall and hence stain purple with Crystal Violet stain. While Gram-negative bacteria with thin peptidoglycan layer in cell wall, appear pink/red when stained with Safranin (a counterstain stain used in the procedure).
Microscopic analysis of bacterial strains.
Catalase test
Different morphological colonies were tested, and they all showed catalase-negative results with no fuming or bubbling (Fig. 8).
Catalase test.
Blood agar hemolysis
Different hemolytic patterns were observed by bacterial strains. Some bacterial strains showed partial hemolysis of RBC’s, some indicated complete lysis and some exhibited no lysis of RBC’s. On the basis of lysis pattern the bacterial strains were observed as:
Alpha-hemolytic strains
In α-hemolysis, the appearance of the blood agar medium was dark greenish due to the formation of biliverdin from Hb (Fig. 9).
α-Hemolysis of bacterial strain.
Beta-hemolytic strains
In β-hemolysis, there was a complete lysis of RBCs that appeared in the form of a light yellowish area under the colony and was transparent. It was caused by an enzyme exotoxin (Streptolysin) that was produced by the bacteria (Fig. 10).
β-hemolysis of bacterial strains.
Gamma-hemolytic strains
No hemolysis was observed. In this case, the blood agar plate appeared brownish. It was a normal reaction of blood to the provided growth conditions of 37 °C and CO2 (Fig. 11).
ɣ-hemolysis of bacterial strains.
Extraction from Chenopodium murale
Extract was obtained from C. murale and 100 g of dried leaves produced 6 g of extract, the yield was calculated with the above-mentioned formula in the methodology.
Antibacterial activity of Chenopodium murale leaves extract
Leaves extract of C. murale was further used to determine its antibacterial activity against the pathogenic bacterium S. mutans isolated on blood agar (Fig. 12).
Isolated colonies of S. mutans on blood agar.
Disc diffusion method
Antibiotic discs of ampicillin and clindamycin were placed on the growth lawns of S. mutans (Fig. 13). The antibiotic discs showed a bacteriostatic zone of inhibition on MHA medium against S. mutans. The diameter of the inhibition zones of antibiotic discs was measured in mm in all the samples.
Zone of inhibition of antibiotic discs and C. murale.
Agar well diffusion method
Plant extract was applied in wells to MHA medium containing S. mutans strains. Antibacterial activity was observed in the plant extract after 24 h. The diameter of the zone of inhibition was measured in all the samples (Fig. 14).
Clindamycin diameter of zone of inhibition.
Clindamycin and ampicillin diameter of zone of inhibition
The diameter of inhibition zones made by the extract was measured at 12 mm and compared with the standard antibiotics; ampicillin and clindamycin, measured at 20 mm and 30 mm, respectively (Figs. 15 and 16).
Ampicillin diameter of zone of inhibition.
C. murale diameter of zone of inhibition.
FTIR analysis of Chenopodium murale extract
FTIR analysis showed alkyl halide, phenyl, carbonyl, alkane, amines, and alcohol functional groups in C. murale extract (Fig. 17). The Fourier Transform Infrared (FTIR) spectroscopy was conducted to identify the functional groups present in the C. murale extract in Table 1. The analysis revealed significant spectral peaks corresponding to various functional groups, detailed in Table 1. The FTIR spectra revealed significant vibrations at 1367 cm−1, 3357 cm−1, 1639 cm−1, 1579 cm−1, 3271 cm−1, and 2856 cm−1, corresponding to various functional groups, including O − H and N − H groups. The C–H group was attributed to the peak at 2856 cm−1, while the carbonyl bonds (C = O) were indicated by the peak at 1639 cm−1, and C − C stretching was observed at 1367 cm−1. These bond stretches, which include C − Br, C − O, C = O, C − H, N − H, and O − H, belong to alkyl halide, phenyl, carbonyl, alkane, amine, and alcohol functional groups, respectively. This analysis suggests that the functional groups identified in C. murale extracts act as biological scavengers, exhibiting bacteriostatic effects against Streptococcus mutans, even at low concentrations. Furthermore, the anti-S. mutans activity of the ethanolic extract was confirmed with a Minimum Inhibitory Concentration (MIC) of 1.469 mg/mL and a Minimum Bactericidal Concentration (MBC) of 4.260 mg/mL, indicating that S. mutans cannot resist this herbal extract.
FTIR spectrum of C. murale extract.
Phytochemical analysis by using TLC
The results of phytochemical analysis (presence of coumarin) in the ethanolic extracts of C. murale by using TLC method are shown in below Table 2. The Rf values were calculated with the help of difference in the mobile phase travelling data for the pure compound (coumarin) and the ethanolic extracts of C. murale. The test was repeated 3 times and calculated as mean for the results.
Minimum inhibitory concentration (MIC) and minimum bactericidal (MBC) concentration
MIC is the lowest concentration of C. murale that inhibits the visible growth of a bacterium. MBC is the lowest concentration of an C. murale agent that kills 99.9% of the bacteria. Minimum Inhibitory Concentration (MIC) for C.murale and 1 µg/mL. Minimum Bactericidal (MBC) Concentration ) for C.murale is 2 µg/mL in Table 3.
Glycolytic pH drop assay
The pH drop was seen significantly declined with the ethanolic extracts of C. murale following incubation at each tested concentration even at lower than their MICs (p < 0.05). The inhibitory actions against S. mutans will be depended on the concentrations of the extract used. The ethanolic extract of C. murale at higher concentration of 1 mg/mLwill be considered for inhibition because maximum pH drop was seen there. No such pH drop was seen in the control group. The effects of the extracts of C. murale on glycolytic pH drop have been shown in Table 4.
Biofilm activity
Inhibition percentages above 50% are considered significant in antimicrobial testing, indicating substantial bacterial growth inhibition. Inhibition percentage of Chenopodium murale against Streptococcus mutan at different concentration presented in the Table 2. At the concentration of 0.8 (µg/mL) Chenopodium murale shows highest inhibition percentage (94%) to inhibit the biofilm formation of Streptococcus mutan have been shown in Fig. 18.
%Age inhibition of Chenopodium murale to inhibit biofilm formation of S mutan.
Discussion
The current study was based on the determination of the antimicrobial potential of a plant extract of C. murale. The ethanolic extract of C. murale showed inhibition zones of varying diameters, of which 12 mm was the maximum diameter of the inhibition zone. This plant extract has significance in the prevention of dental caries through its addition to tooth paste, mouth washes, and other drugs. In the current study, a novel plant extract of C. murale was used to determine its functionality against the oral cavity-occupying bacterium S. mutans, which causes dental caries. Likewise, in a study, the development of nanoparticles proved helpful in reducing caries number and its prevalence in the community, as they degenerate exo-polysaccharides synthesized by S. mutans and thus decline the bacterial growth rate19. In contrast to our study, where an extract of C. murale leaves was applied, different studies used different plant parts. Similarly, the leaves of C. murale have notable antibacterial efficacy, especially against Streptococcus mutans, the principal bacterium implicated in tooth cavities. The ethanolic extract of C. murale strongly inhibited the development of S. mutans and suppressed its cariogenic activities associated with acid generation that causes tooth demineralization. C. murale presents a promising possibility for use into oral health-care products designed to reduce dental caries. The extract’s capacity to sustain antimicrobial effectiveness at minimal concentrations, as demonstrated in this work, indicates its potential incorporation into mouthwashes, toothpastes, and other oral hygiene products for effective caries prevention. Moreover, the inclusion of bioactive substances such coumarin in C. murale leaves enhances its inhibitory effects, offering a natural option for sustaining dental health20. In our study, a shaking incubator was used for 3 days, followed by filtration to obtain C. murale extract, while in another study, gamma radiation was used for the synthesis of pomegranate and green tea extracts. The efficacy of both of these plant extracts increased in their combined ratio against S. mutans and in the prevention of dental caries21.
In a study, cinnamon-based water extract played a role in inhibiting caries development by controlling the synthesis of exo-polysaccharides by S. mutans as well as inhibiting the function of gtf enzymes and acid release by the bacterial biofilms22. It is similar to our selected C. murale ethanolic extract. This phenomenon is mostly ascribed to cinnamaldehyde, a significant chemical constituent of cinnamon, which has demonstrated the ability to interfere with bacterial biofilms and regulate the production of exo-polysaccharides. Likewise, our chosen ethanolic extract of C. murale demonstrates similar benefits, perhaps attributable to the presence of bioactive components such coumarin, recognized for its antibacterial and anti-inflammatory characteristics. This indicates that C. murale extract may also impede S. mutans biofilm growth and acid generation, hence supporting its potential function in caries prevention.
Similarly, the plant C. colocynthis showed antibacterial potential against S. mutans. The researchers applied an alcohol-based extract of C. colocynthis fruit that indicated higher efficacy in preventing S. mutans proliferation and also prohibited its cariogenic property. The aqueous extract of this plant also possessed strong antibacterial activity at higher concentrations23. As our subject plant showed antimicrobial activity besides other medicinal properties related to its chemical compounds, it is similar to a study in which a plant named Buah Merah exhibited such chemical-based antimicrobial activity against S. mutans. In our study, the inhibition zone of C. murale ethanol extract was 12 mm, while in another study, Buah Merah methanol ethyl-acetate exhibited a 16.25 mm diameter zone of inhibition24. In our study, we have compared the effectiveness of C. murale with antibiotic discs against S. mutans. Similarly, in a study, herbal-based oral cleaners and fluoride-based cleaners were compared to determine their higher efficacy against S. mutans. It showed a higher inhibition rate when using herbal-based oral rinses rather than fluoride rinses25.
In our study, the antimicrobial potential of C. murale was measured by its maximum inhibition zone diameter of 12 mm, just like a study depicted S. xanthocarpum bacteriostatic potential on S. mutans with an inhibitory diameter of 30 mm less than that of the standard drug CHX inhibition diameter of 32 mm26. In our study, the diameter of inhibition zone 12 mm was less than that of standard antibiotics (Clindamycin inhibition zone 30 mm), which possibly contributed to a greater diffusion rate across the agar medium or the applied dosage of drug and plant extract. Likewise, in a study, the plant extract of P. lentiscus on S. mutans showed a 31 mm zone of inhibition diameter that was less than that of the standard antibiotic inhibition zone of 32 mm27. Similarly, in our study, C. murale indicated 12 mm, which was less than the ampicillin inhibitory diameter of 20 mm.
A study demonstrated that the application of the methanolic extract of the peel part of lime in its higher concentrations proved more effective than other synthetic drugs such as CHX, which have a lot of hazardous effects on health in comparison to herbal-based antimicrobial products28,29. Similarly, in our study, the use of an ethanol plant extract of C. murale proved effective and safer than synthetic antibiotics. A study illustrated how the application of herbal-based mouthwash made from T. polium that possessed major phenol constituents proved helpful in declining the growth rate of S. mutans30. Similarly, in our study, the use of C. murale proved to be effective against reducing dental caries-causing bacteria S. mutans. In another study, it was reported that the presence of tannin constituents in T. polium proved effective in decreasing the enzyme efficacy of bacteria as well as minimizing their cariogenic potential. Just like in our study, the chemical compounds present in C. murale declined S. mutans growth in medium31. In a study, it has been illustrated that gram-positive Strep species occur at a higher rate in caries patients32. Similarly, in our study, we selected S. mutans due to its higher prevalence in caries patients. In a study, it was observed that the extract of garlic showed bacteriostatic activity only when it was applied at a higher concentration33. But in our study, the extract of C. murale showed antibacterial activity at a much lower concentration.
The FTIR spectra of C. murale extract revealed significant vibrations at 1367 cm−1, 3357 cm−1, 1639 cm−1, 1579 cm−1, 3271 cm−1, and 2856 cm−1, indicating the presence of O − H and N − H functional groups. The C − H group was identified at 2856 cm−1, and carbonyl bonds (C = O) appeared at 1639 cm−1. Additionally, stretches corresponding to C-Br, C-O, C = O, C-H, N-H, and O-H were detected in the ranges of 700–900 cm−1 to 3300–3500 cm−1, representing various functional groups. Previous studies have also shown similar band stretches in C. murale, further confirming the presence of biologically relevant compounds. The identified functional groups suggest that the extract acts as a biological scavenger, exhibiting bacteriostatic effects against Streptococcus mutans even at low concentrations, indicating that this herbal extract may be an effective alternative to standard antibiotics. The anti-S. mutans activity of the C. murale ethanolic extract was found with the MIC of 1.469 mg/mL and MBC of 4.260. This study is in agreement with the inhibitory activities of the aqueous and methanolic extracts of C. murale against cariogenic properties of S. mutans8,34. The ethanolic extracts of C. murale at every tested concentration (lower than their MICs) also inhibited the cariogenic properties of S. mutans, i.e. linked to pH drop significantly35. Further, the quantitative evaluation of other phytochemical marker could be used in standardization of the extract for the identification of chemical constituent attributed to pharmacological activity. Although there are many biological active components presented in the extracts but we selected only coumarin, as a major bioactive phytochemical in the ethanolic extracts of C. murale for the treatment of dental carries.
Conclusions
This study demonstrated that ethanolic extracts of Chenopodium murale markedly prevented the proliferation of Streptococcus mutans and mitigated its cariogenic characteristics by reducing the pH, linked to the bacteria’s acid generation. This impact was noted even at doses beneath the minimal inhibitory concentration (MIC). The extract had significant inhibitory effect against S. mutans, the principal bacteria implicated in dental caries, with efficacy akin to that of conventional antibiotics like ampicillin and clindamycin. S. mutans exhibited a restricted capacity to withstand the herbal extract, presumably due to the presence of scavenging chemicals, as evidenced by the FTIR spectrum. The physiologically active ingredient, coumarin, was validated in the pure extract by the Thin Layer Chromatography (TLC) technique. The minimum inhibitory concentration (MIC) and minimum bactericidal concentration (MBC) of the ethanolic extract of C. murale were determined to be 1.469 mg/mL and 4.260 mg/mL, respectively. Our research indicates that C. murale extract possesses considerable potential as an active component in oral healthcare products for the prevention of dental caries. Due to its potent inhibitory effects at minimal concentrations, only limited quantities of the extract are necessary for the development of effective oral health-care products.
Data availability
All the data of this study contained in the manuscript and for further on this study can be obtained from corresponding author Shazia Parveen at drshazia.zool@wum.edu.pk.
References
Akrayi, H. F. Antibacterial potency of aqueous plant extracts against Streptococcus mutans. Med. J. Islamic World Acad. Sci. 109 (1566), 1–5 (2014).
Sroussi, H. Y. et al. Common oral complications of head and neck cancer radiation therapy: mucositis, infections, saliva change, fibrosis, sensory dysfunctions, dental caries, periodontal disease, and osteoradionecrosis. Cancer Med. 6 (12), 2918–2931 (2017).
Saputo, S., Faustoferri, R. & Quivey, R. A drug repositioning approach reveals that Streptococcus mutans is susceptible to a diverse range of established antimicrobials and nonantibiotics. Antimicrob. Agents Chemother. 62 (1), 01674–01617. https://doi.org/10.1128/aac (2018).
Choubey, A. et al. Potential of medicinal plants in kidney, gall and urinary stones. Int. J. Drug Dev. Res. 2 (2), 431–447 (2010).
Soares-Bezerra, R. J. et al. Natural products as a source for new anti-inflammatory and analgesic compounds through the Inhibition of purinergic P2X receptors. Pharmaceuticals 6 (5), 650–658 (2013).
Chowdhury, J. et al. Antibacterial and cytotoxic activity screening of leaf extracts of Vitex negundo (Fam: Verbenaceae). J. Pharm. Sci. Res. 1 (4), 103 (2009).
Fuentes-Bazan, S., Uotila, P. & Borsch, T. A novel phylogeny-based generic classification for Chenopodium sensu Lato, and a tribal rearrangement of Chenopodioideae (Chenopodiaceae). Willdenowia 42 (1), 5–24 (2012).
Ahmed, O. H., Hamad, M. N. & Jaafar, N. S. Phytochemical investigation of Chenopodium murale (Family: Chenopodiaceae) cultivated in Iraq, isolation and identification of Scopoletin and Gallic acid. Asian J. Pharm. Clin. Res. 10 (11), 70–77 (2017).
List, B. Botanical Society of Britain and Ireland. Archived from the Original Xls (2007).
Boulos, L. Medicinal Plants of North Africa (1983).
Gohar, A. A., Maatooq, G. T. & Niwa, M. Two flavonoid glycosides from Chenopodium murale. Phytochemistry 53 (2), 299–303 (2000).
Abdel-Aziz, M. S. et al. Antioxidant and antibacterial activity of silver nanoparticles biosynthesized using Chenopodium murale leaf extract. J. Saudi Chem. Soc. 18 (4), 356–363 (2014).
Albert, M. et al. Gram stain is a poor predictor of final culture result in ICU patients with suspicion of ventilator-associated pneumonia: 10. Crit. Care Med. 34 (12), A3 (2006).
Nunki, N., Mutiarawati, D. T. & Prayekti, E. Purple sweet potato (Ipomoea Batatas L.) peels extract as an alternative dye for bacteria gram staining. Indonesian J. Med. Lab. Sci. Technol. 2 (2), 76–84 (2020).
Penney, D. et al. Analysis and testing of biological stains—The biological stain commission procedures. Biotech. Histochem. 77, 237–275 (2002).
Arora, S. & Itankar, P. Extraction, isolation and identification of flavonoid from Chenopodium album aerial parts. J. Traditional Complement. Med. 8 (4), 476–482 (2018).
Ajagannanavar, S. L. et al. Effect of aqueous and alcoholic licorice (glycyrrhiza glabra) root extract against Streptococcus mutans and lactobacillus acidophilus in comparison to chlorhexidine: an in vitro study. J. Int. Oral Health. 6 (4), 29 (2014).
Yang, Y. et al. Effect of LongZhang gargle on biofilm formation and acidogenicity of Streptococcus mutans in vitro. BioMed Res. Int. 2016, 1 (2016).
Gao, L. et al. Nanocatalysts promote Streptococcus mutans biofilm matrix degradation and enhance bacterial killing to suppress dental caries in vivo. Biomaterials 101, 272–284 (2016).
Tsujii, T. et al. Antibacterial activity of phellodendron bark against Streptococcus mutans. Microbiol. Immunol. 64 (6), 424–434 (2020).
Abd-El, A. B. E. D. & Sallam, R. A. Antibacterial effect of green tea and pomegranate Peel extracts on Streptococcus mutans of orthodontic treated patients. J. Radiation Res. Appl. Sci. 13 (1), 132–143 (2020).
Alshahrani, A. M. & Gregory, R. L. In vitro cariostatic effects of cinnamon water extract on nicotine-induced Streptococcus mutans biofilm. BMC Complement. Med. Ther. 20, 1–9 (2020).
Kafshgari, H. S. et al. The effect of Citrullus colocynthis extracts on Streptococcus mutans, Candida albicans, normal gingival fibroblast and breast cancer cells. J. Biol. Research-Bollettino Della Società Italiana Di Biol. Sper. 92 (1), 1 (2019).
Damayanti, L. et al. Antibacterial activity of Buah Merah (Pandanus conoideus Lam.) against bacterial oral pathogen of Streptococcus sanguinis ATCC10556, Streptococcus mutans ATCC 25175, and Enterococcus faecalis ATCC 29212: an in vitro study. Open. Dentistry J. 14 (1), 113–119 (2020).
Somaraj, V. et al. Effect of herbal and fluoride mouth rinses on Streptococcus mutans and dental caries among 12–15-year-old school children: A randomized controlled trial. Int. J. Dent. 2017, 1 (2017).
Mahalakshmi, P. et al. Evaluation of antimicrobial properties of Solanum xanthocarpum and Pistacia lentiscus extracts on Streptococcus mutans, Lactobacillus species and Actinomyces viscosus: an in vitro study. J. Oral Maxillofacial Pathol. 23 (3), 383 (2019).
Jeffrey, J. et al. Inhibition of Streptococcus mutans growth induced by the extract of citrus aurantifolia Peel. J. Int. Dent. Med. Res. 13 (1), 122–127 (2020).
Saima, S. & Ahmed, R. Efficacy of chlorhexidine vs herbal mouthwash in college students: A comparative study. Int. J. Appl. Dent. Sci. 5 (2), 403–406 (2019).
Khoramian Tusi, S. et al. The effect of antimicrobial activity of Teucrium polium on oral Streptococcus mutans: a randomized cross-over clinical trial study. BMC Oral Health. 20, 1–8 (2020).
Seabra, R. M. et al. Anti-oxidant compounds extracted from several plant materials. Biomaterials Aquat. Terr. Organisms. 1, 115–174 (2006).
McNally, L. & Brown, S. P. Building the Microbiome in health and disease: niche construction and social conflict in bacteria. Philosophical Trans. Royal Soc. B: Biol. Sci. 370 (1675), 20140298 (2015).
Houshmand, B., Mahjour, F. & Dianat, O. Antibacterial effect of different concentrations of Garlic (Allium sativum) extract on dental plaque bacteria. Indian J. Dent. Res. 24 (1), 71–75 (2013).
Mohan, C. O., Gunasekaran, S. & Ravishankar, C. Chitosan-capped gold nanoparticles for indicating temperature abuse in frozen stored products. NPJ Sci. Food. 3 (1), 2 (2019).
Abd Elkarim, A. S. et al. Synadenium grantii Hook F.: HPLC/QTOF-MS/MS tentative identification of the phytoconstituents, antioxidant, antimicrobial and antibiofilm evaluation of the aerial parts. Rasayan J. Chem. 14, 811–828 (2021).
Mohammed, H. A. et al. Phytochemical profiling, in vitro and in Silico anti-microbial and anti-cancer activity evaluations and Staph gyraseb and h-TOP-IIβ receptor-docking studies of major constituents of Zygophyllum coccineum L. Aqueous-ethanolic extract and its subsequent fractions: an approach to validate traditional phytomedicinal knowledge. Molecules 26 (3), 577 (2021).
Acknowledgements
The authors would like to extend their sincere appreciation to the Researchers Supporting Project Number (RSP2025R457), King Saud University, Riyadh, Saudi Arabia.
Funding
This study is supported by the project grant (RSP2025R457) was received from King Saud University, Riyadh, Saudi Arabia to support this research.
Author information
Authors and Affiliations
Contributions
S.K: Conceptualization, Methodology, Writing - original draft. Investigation; S.P: Conceptualization, Methodology, Formal Analysis, Supervision, Visualization, Writing - original draft; H.H: Validation, Visualization, Writing - review & editing, ; S.T. Formal analysis, Visualization, Writing - review & editing; R.R. Visualization, Validation, Writing - review & editing, M.R: Conceptualization, Data Curation, Writing - review & editing, Investigation; S.B.; Data curation, Visualization, Formal analysis Writing - review & editing; K.Z.; Formal analysis, Resources, Data curation; A.I; Formal analysis, Data curation, Visualization, Funding acquisition, Writing - review & editing, K.K-M.; Validation, Investigation, Writing - review & editing; S.F.; Visualization, Writing-review & Editing, Validation; A.A.: Data curation; Methodology, Funding acquisition, Writing - review & editing; M.K: Conceptualization, Supervision, Validation, Visualization, Writing - review & editing, Y.A. B. J: Funding acquisition, Project administration, Formal analysis, Writing - review & editing.All authors have read and agreed to the published version of the manuscript.
Corresponding authors
Ethics declarations
Competing interests
The authors declare no competing interests.
Ethical approval
This is certified that patients’ proforma-based ethical permission and informed consent was obtained for the collection of saliva samples from patients and the study was carried out in compliance with guidelines of EU Directive 2001/20/EU for human experiments and in accordance with guidelines or the National Research Council’s Guide for the Care and Use of human and received approval from the Ethical Committee The Women University Multan under the approval number WUM/UREC/20–00028. This is to certify that there are no human images, videos, names, or any other form of human identification included in this study, which was conducted in accordance with the ethical guidelines of the Declaration of Helsinki.
Additional information
Publisher’s note
Springer Nature remains neutral with regard to jurisdictional claims in published maps and institutional affiliations.
Rights and permissions
Open Access This article is licensed under a Creative Commons Attribution-NonCommercial-NoDerivatives 4.0 International License, which permits any non-commercial use, sharing, distribution and reproduction in any medium or format, as long as you give appropriate credit to the original author(s) and the source, provide a link to the Creative Commons licence, and indicate if you modified the licensed material. You do not have permission under this licence to share adapted material derived from this article or parts of it. The images or other third party material in this article are included in the article’s Creative Commons licence, unless indicated otherwise in a credit line to the material. If material is not included in the article’s Creative Commons licence and your intended use is not permitted by statutory regulation or exceeds the permitted use, you will need to obtain permission directly from the copyright holder. To view a copy of this licence, visit http://creativecommons.org/licenses/by-nc-nd/4.0/.
About this article
Cite this article
Kanwal, S., Perveen, S., Hameed, H. et al. Evaluating the efficacy of Chenopodium murale plant extract in inhibiting Streptococcus mutans and reducing dental caries risk. Sci Rep 15, 15406 (2025). https://doi.org/10.1038/s41598-025-00127-x
Received:
Accepted:
Published:
Version of record:
DOI: https://doi.org/10.1038/s41598-025-00127-x